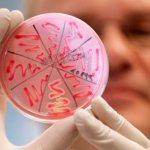
image
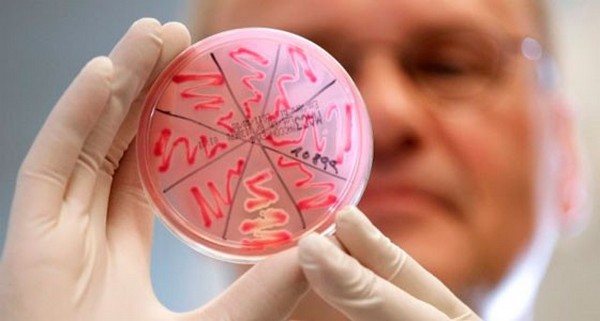
image

Что такое менингит
Это воспаление мозговых оболочек, окружающих головной и спинной мозг с увеличением числа клеток в спинномозговой жидкости. Головной и спинной мозг окружены снаружи защитными оболочками из соединительной ткани, которые называются оболочки мозга. Эти оболочки могут быть заражены различными патогенными микроорганизмами. Воспалительный процесс называется менингитом. Если инфекция касается самого мозга, наступает менингоэнцефалит.
Инкубационный период болезни составляет от 2 до 10 суток. Чаще инфекция начинается остро с подъёма температуры, которая может достигать 42˚. В сроки от нескольких часов до нескольких суток появляется интенсивно нарастающая головная боль. Терпеть боль и жар не следует, но самостоятельно сбивать температуру также не рекомендуется. Лучше всего вызвать скорую медицинскую помощь или незамедлительно обратиться к врачу. Так как температура повышается из-за воспаления, её понижение не означает выздоровление. К тому же, сбить температуру в домашних условиях не всегда удаётся.
Менингит всегда следует рассматривать как чрезвычайную ситуацию. Без лечения он может привести к летальному исходу заболевшего.
Как в результате перенесённой инфекции, так и в результате носительства, формируется стойкий иммунитет к болезни.
Лечение
Любые воспалительные процессы в организме – это очень серьезно. А если воспаление протекает в мозге, то ни о каком самолечении дома и речи быть не может. Ни народные способы, ни средства альтернативной медицины не смогут заменить необходимую медикаментозную терапию. Менингит должен лечить только врач и только в больнице. Чем быстрее больной обратиться за помощью к специалисту, тем выше его шансы на выживание.
Комплексную программу лечения врач может составить только после получения результатов обследований пациента. Меж тем в случае с менингитом, когда счет идет на часы, нельзя терять ни минуты. В качестве экстренной помощи всем пациентам с подозрением на менингит назначают антибиотики широкого спектра действия. В начале лечения врач может прописать препараты из группы пенициллинов, цефалоспоринов, макролидов. Это позволит обезвредить бактерии, вызывающие гнойной менингит. Чтобы антибиотики начали действовать немедленно, лекарство обычно вводят внутривенно (капельница), а в очень тяжелых случаях – непосредственно в ликвор. Лечение серозного менингита проводят с дополнительным использованием противовирусных препаратов. Помимо специфической подобранной по чувствительности антибактериальной или противовирусной терапии, больным назначают ноотропные и сосудистые препараты – Ноотропил, Пирацетам или их аналоги принимают, чтобы восстановить нервные клетки и состояние сосудов. В качестве противовоспалительных средств врачи проводят гормональную терапию пациентам такими препаратами, как Преднизолон, Дексаметазон, Метилпреднизолон либо Гидрокортизон.
Также в схеме лечения менингита используются диуретическая терапия. Мочегонные лекарства необходимы для снятия отека мозга.
Независимо от формы и стадии менингита, детям и взрослым всегда назначают витамины и минералы. Эти вещества необходимы для поддержания иммунитета, который при воспалении мозга всегда снижен, а также для восстановления запасов нутриентов, необходимых для правильного функционирования систем и органов больного.
Какие формы бывают
Существуют разные формы данной инфекции. Она может быть первичной или вторичной, развиваясь на фоне уже существующего заболевания. В основном они различаются по причине заражения.
- Бактериальный или гнойный менингит
Данный вид вызывается бактериями. Он проходит в тяжёлой форме и часто является опасным для жизни. Этот вид инфекции всегда требует неотложной медицинской помощи.
- Асептический
Под такой формой подразумевается синдром острого начала менингеальных симптомов с высокой температурой и повышенным количеством клеток в цереброспинальной жидкости.
- Вирусный менингит
Это одна из форм асептического менингита. Он протекает легче, чем бактериальный. Если этот вид инфекции ограничивается только мозговой оболочкой, не наступает воспаление, то заболевание часто может проходить спонтанно само по себе, без вмешательства специалистов.
У молодых людей чаще встречаются безобидные формы вирусного менингита, у пожилых — бактериальные, более тяжёлые формы.
Чем опасен менингит? — Последствия заболевания
Конечно, гнойный процесс опаснее, чем серозный. Поэтому чаще всего осложнения можно разобрать на примере эпидемического цереброспинального менингита, вызванного менингококковой инфекцией. Наиболее часто развиваются следующие состояния:
- септический шок;
- отек – набухание головного мозга с последующей дислокацией его вещества, развитием различных вариантов вклинений, является наиболее частой причиной смерти в первые сутки развития заболевания;
- переход инфекции с оболочек на вещество коры головного мозга, с присоединением очаговой симптоматики — развитие менингоэнцефалита;
- грозным осложнением является окклюзионная гидроцефалия. При этом спайки, которые в изобилии располагаются в ликворных путях после гнойного процесса, способны в большей или меньшей степени перекрывать эти пути. В результате развивается быстропрогрессирующий синдром внутричерепной гипертензии.
Любой гнойный менингит, последствия которого не могут быть предварительно спрогнозированы, обязательно должен лечиться в отделении нейроинфекции инфекционного стационара или в отделении реанимации.
Что вызывает воспаление оболочек головного мозга
Частыми возбудителями являются бактерии и вирусы, реже – грибки, паразиты. Микробы передаются воздушно-капельным путём, при чихании или кашле. Многие люди носят вызывающие инфекцию организмы без развития самой болезни, то есть являются просто носителями.
Такие бактерии, как менингококковая, пневмококковая и гемофильная являются частыми возбудителями менингита. Также у больных туберкулёзом, сифилисом может развиваться воспаление. Иногда может произойти прямое попадание и распространение инфекции, например, при черепно-мозговой травме с переломом черепа или инфекции среднего уха.
Вирусный менингит часто наблюдается в связи с другими вирусными заболеваниями. Например, до 40% больных паротитом имеют данную инфекцию. Наиболее распространённым вирусным менингоэнцефалитом является клещевой энцефалит, который передаётся от укусов клещей. Этот вид вызывают аденовирусы.
Воспалению оболочек головного мозга в основном подвержены люди с ослабленной иммунной системой. В зоне риска пожилые люди, маленькие дети, больные сахарным диабетом, раком, алкоголики. Лица, с некоторыми врождёнными дефектами иммунной системы, имеют предрасположенность к возникновению воспаления.
Причины и факторы риска
Возбудитель болезни менингококк Вексельбаума — Neisseria meningitidis. Он представляет собой диплококк, неподвижный, жгутиков и капсул не имеет, спор не образует. Культивируется на средах, содержащих человеческий или животный белок. Оптимальная температура для роста — 37°С. Различают серотипы А, В, С менингококка, дополнительно описаны другие серогруппы (X, Y, Z и др.).
Несмотря на то, что самая высокая заболеваемость в нашей стране наблюдалась в 1973 году (9,6 на 100 тыс. населения), повышенный ее уровень сохраняется вплоть до настоящего времени (2-2,5 на 100 тыс. населения). При этом у детей она составляет 7, 32 на 100 тыс. детей до 17 лет (данные за 2006 г). Таким образом менингококковой инфекцией болеют лица любого возраста, однако на долю детей приходится до 80% всех случаев.
Уровень смертности при менингококковой инфекции во всех возрастных группах остается на уровне 10%, летальность среди подростков приближается к 25%. Имеет место и генетическая предрасположенность к заболеванию, связанная с врожденным дефицитом терминальных компонентов комплемента (С5-С9), С3 и пропердина.
Традиционно болезнь относится к «стрессовым» инфекциям, поскольку рост заболеваемости прямо коррелирует с войнами, а также крупными катастрофами и авариями, ростом социальной напряженности. Практически любая ситуация, приводящая к стрессу, с одной стороны, и к значительной скученности людей в плохих бытовых условиях — с другой, характеризуется высоким риском возникновения менингококковой инфекции.
Менингококковая болезнь чаще встречается среди больных СПИДом, чем среди населения в целом. Другие факторы, которые могут увеличить риск, включают:
- заражение вирусной инфекцией;
- проживание в переполненном доме;
- хроническое заболевание;
- курение или вдыхание сигаретного дыма (пассивное курение).
Заражение происходит воздушно-капельным путем при непосредственном контакте с носителем на расстоянии менее 0,5 метров и длительности не менее 2 часов. Характерен подъем заболеваемости в холодное время года с октября по апрель.
Симптомы
Взрослый человек, страдающий воспалением мозговых оболочек, имеет следующие симптомы, сопутствующие этому заболеванию:
- сильная головная боль, постепенно нарастающая, часто нестерпимая;
- высокая температура;
- ригидность затылочных мышц (все движения головы, особенно, такие как наклоны головы, прижимание подбородка к груди чрезвычайно болезненны или вообще невозможны),
- судороги,
- снижение сознания.
Часто приходят усталость, истощение, светобоязнь, чувствительность к шуму, возможны тошнота, рвота. На поздних стадиях может наступить сонливость и кома.
Что может происходить при менингите у детей? У малышей симптомы бывают менее выражены. Здесь на первое место выступают боли в животе, понос, иногда судороги.
К сожалению, даже после успешной терапии менингита, могут остаться умеренные головные боли, незначительные судороги, неспособность длительно концентрироваться. Возникают острые реакции на переутомление и стресс. Снизить боль в этих случаях могут народные средства, травяные сборы, настойки из лекарственных трав (например, липовый, ромашковый чай, настойка лаванды лекарственной).
Может ли быть без температуры?
В некоторых случаях менингит может протекать без температуры. Это бывает только при вирусном менингите. У детей раннего возраста не наблюдается температура., единственными симптомами здесь будут раздражительность, заторможенность, отказ или плохой приём пищи, рвота.
Бывают случаи, что у пациентов наблюдается даже понижение температуры.
Бактериальные формы менингита всегда сопровождаются высокой температурой тела.
Несмотря на наличие или отсутствие высокой температуры тела, при сильных головных, затылочных болях, ранее не испытываемых, обязательно следует обратиться к врачу!
Медицинская диагностика — как выявить окончательно?
В первую очередь врач осматривает пациента (проверка давления, измерение пульса и температуры). Далее, врач может назначить анализы и процедуры:
- Анализ крови на наличие микроорганизмов.
- Рентген грудной клетки (для обнаружения признаков пневмонии).
-
Доктор может направить на люмбальную пункцию (для взятия спинномозговой жидкости на анализ). Выглядит процедура следующим образом: в область между 3 и 4 поясничным позвонком вводится специальная тонкая игла для забора жидкости для исследования. Результаты анализа станут известны в течение нескольких часов.
Люмбальная пункция хоть и не является приятной процедурой, всё же не очень болезненна. Во всяком случае, отказываться от неё не стоит, ведь зачастую только таким способом можно определить точный диагноз и узнать причину болезни. Для обезболивания используются анестетики.
После проведённых исследований, врач пропишет соответствующее лечение. Подробнее про проведение диагностических мероприятий читайте в этой статье.
Менингит у детей
Около 80% заболевших приходится на детей и подростков. Из них 50% — это дети до трёх лет. Признаки воспалений у детей отличаются от симптомов у взрослых. У детей до года признаками менингита может быть:
- деформация родничка;
- бледные конечности;
- руки и ноги мёрзнут;
- ноги ребёнка болят;
- дети выглядят ленивыми и апатичными.
Сигнал тревоги, когда малыш не может коснуться подбородка своей ногой. Из-за серьёзных последствий следует проконсультироваться с врачом.
У детей старшего возраста основные жалобы приходятся на плохое здоровье и раздражительность, головные боли.
Форма вирусного воспаления, которой больше подвержены дети и подростки до 14-15 лет, это энтеровирусный или серозный менингит. Он передаётся орально-фекальным путём через загрязнённую воду, грязные руки, немытые овощи.
Симптомы энтеровирусной инфекции у детей: высокая температура, интоксикация, головная боль, сыпь на конечностях. Избежать этого заболевания поможет личная гигиена, употребление в пищу хорошо обработанных продуктов питания и чистой воды, не использование чужих предметов гигиены и столовых приборов.
В схему обязательной вакцинации детей входит прививка от так называемой гемофильной инфекции, она также помогает избежать некоторых видов вирусного менингита.
Последствия и осложнения
В большинстве зафиксированных случаев патология у взрослого человека проходит без осложнений, а выздоровление наступает спустя 7-14 дней. Однако менингит без повышения температуры может вызвать ряд последствий у взрослого пациента. В 10% случаев могут развиться такие явления: нарушения сна, потеря работоспособности, вялость, головные боли, ухудшение координации в пространстве, легкие нарушения памяти и внимания. Такая симптоматика проходит самостоятельно за несколько недель или месяцев.
Для детей менингит без температуры более опасен. Из-за риска несвоевременной диагностики, когда заболевание путают с ОРВИ, могут развиться следующие последствия:
- тугоухость;
- невозможность сосредоточиться на простых задачах;
- ухудшение памяти;
- косоглазие;
- задержка развития.
Поскольку отсутствие температуры при воспалении является признаком слабости иммунитета, не исключен рецидив заболевания. Чтобы его предотвратить, назначают курс иммуномодулирующих препаратов не только во время терапии, но и после нее.
Как подтвердить диагноз?
Диагностика изначально основана на внешнем медосмотре, который обычно обеспечивает чёткие доказательства наличия заболевания. Наблюдая, как пациент выполняет тесты (наклон головы из положения лёжа на спине, сгибание ног в коленных суставах), опытный специалист заметит ригидность мышц.
При подозрении на воспаление должна быть выполнена спинномозговая пункция. Для этого специальной пункционной иглой из канала спинного мозга берётся часть жидкости, которая омывает спинной и головной мозг. Укол делается между 3-м и 5-м поясничным позвонком. Жидкость исследуются на наличие инфекции и патогенов.
Кроме того, сдаётся кровь на анализ. Помимо признаков воспаления и патогенных микроорганизмов, с помощью анализа определяется уровень прокальцитонина в крови. Он увеличивается только при бактериальной форме заболевания.
С помощью компьютерной томографии или магнитно-резонансной томографии исследуется мозг или то место, из которого распространилась инфекция (например, ухо или придаточные пазухи носа).
Как распознать болезнь у себя самостоятельно: некоторые тесты и проверки
Самостоятельно распознать болезнь достаточно сложно без медицинской помощи, но всё же имеется ряд особых симптомов, благодаря которым можно понять что у тебя менингит:
- Симптом Кернига — больной не может разогнуть согнутые в коленях ноги. Можно проверить следующим образом: пациента кладут на спину и он сгибает ногу под углом 90 градусов в коленном и тазобедренном суставах, после чего пробует разогнуть. При наличии менингита, он не сможет этого сделать.
- Симптом Брудзинского — группа характерных симптомов, которые делятся на:
- Средний симптом — если надавить на лобок пациента, ноги согнутся в коленном и тазобедренном суставах.
- Нижний симптом — при сгибании одной ноги (в позиции лёжа), другая подтягивается к животу.
- Щёчный симптом — если надавить на щёку, у больного будут подниматься плечи и сгибаться руки в локтях.
- Симптом Бехтерева — больному следует легонько постучать по скуле, и в случае менингита произойдёт сокращение мышц лица.Ригидность затылка — когда больной не может согнуть голову к области грудной клетки. ВНИМАНИЕ! Даже в случае, если вы установили себе диагноз самостоятельно, это не отменяет вызова врача. Важно знать, что самолечение недопустимо, поскольку таким образом можно нанести непоправимый вред своему здоровью. Последствия менингита могут иметь печальный финал, вплоть до летального исхода, ели нет лечения.